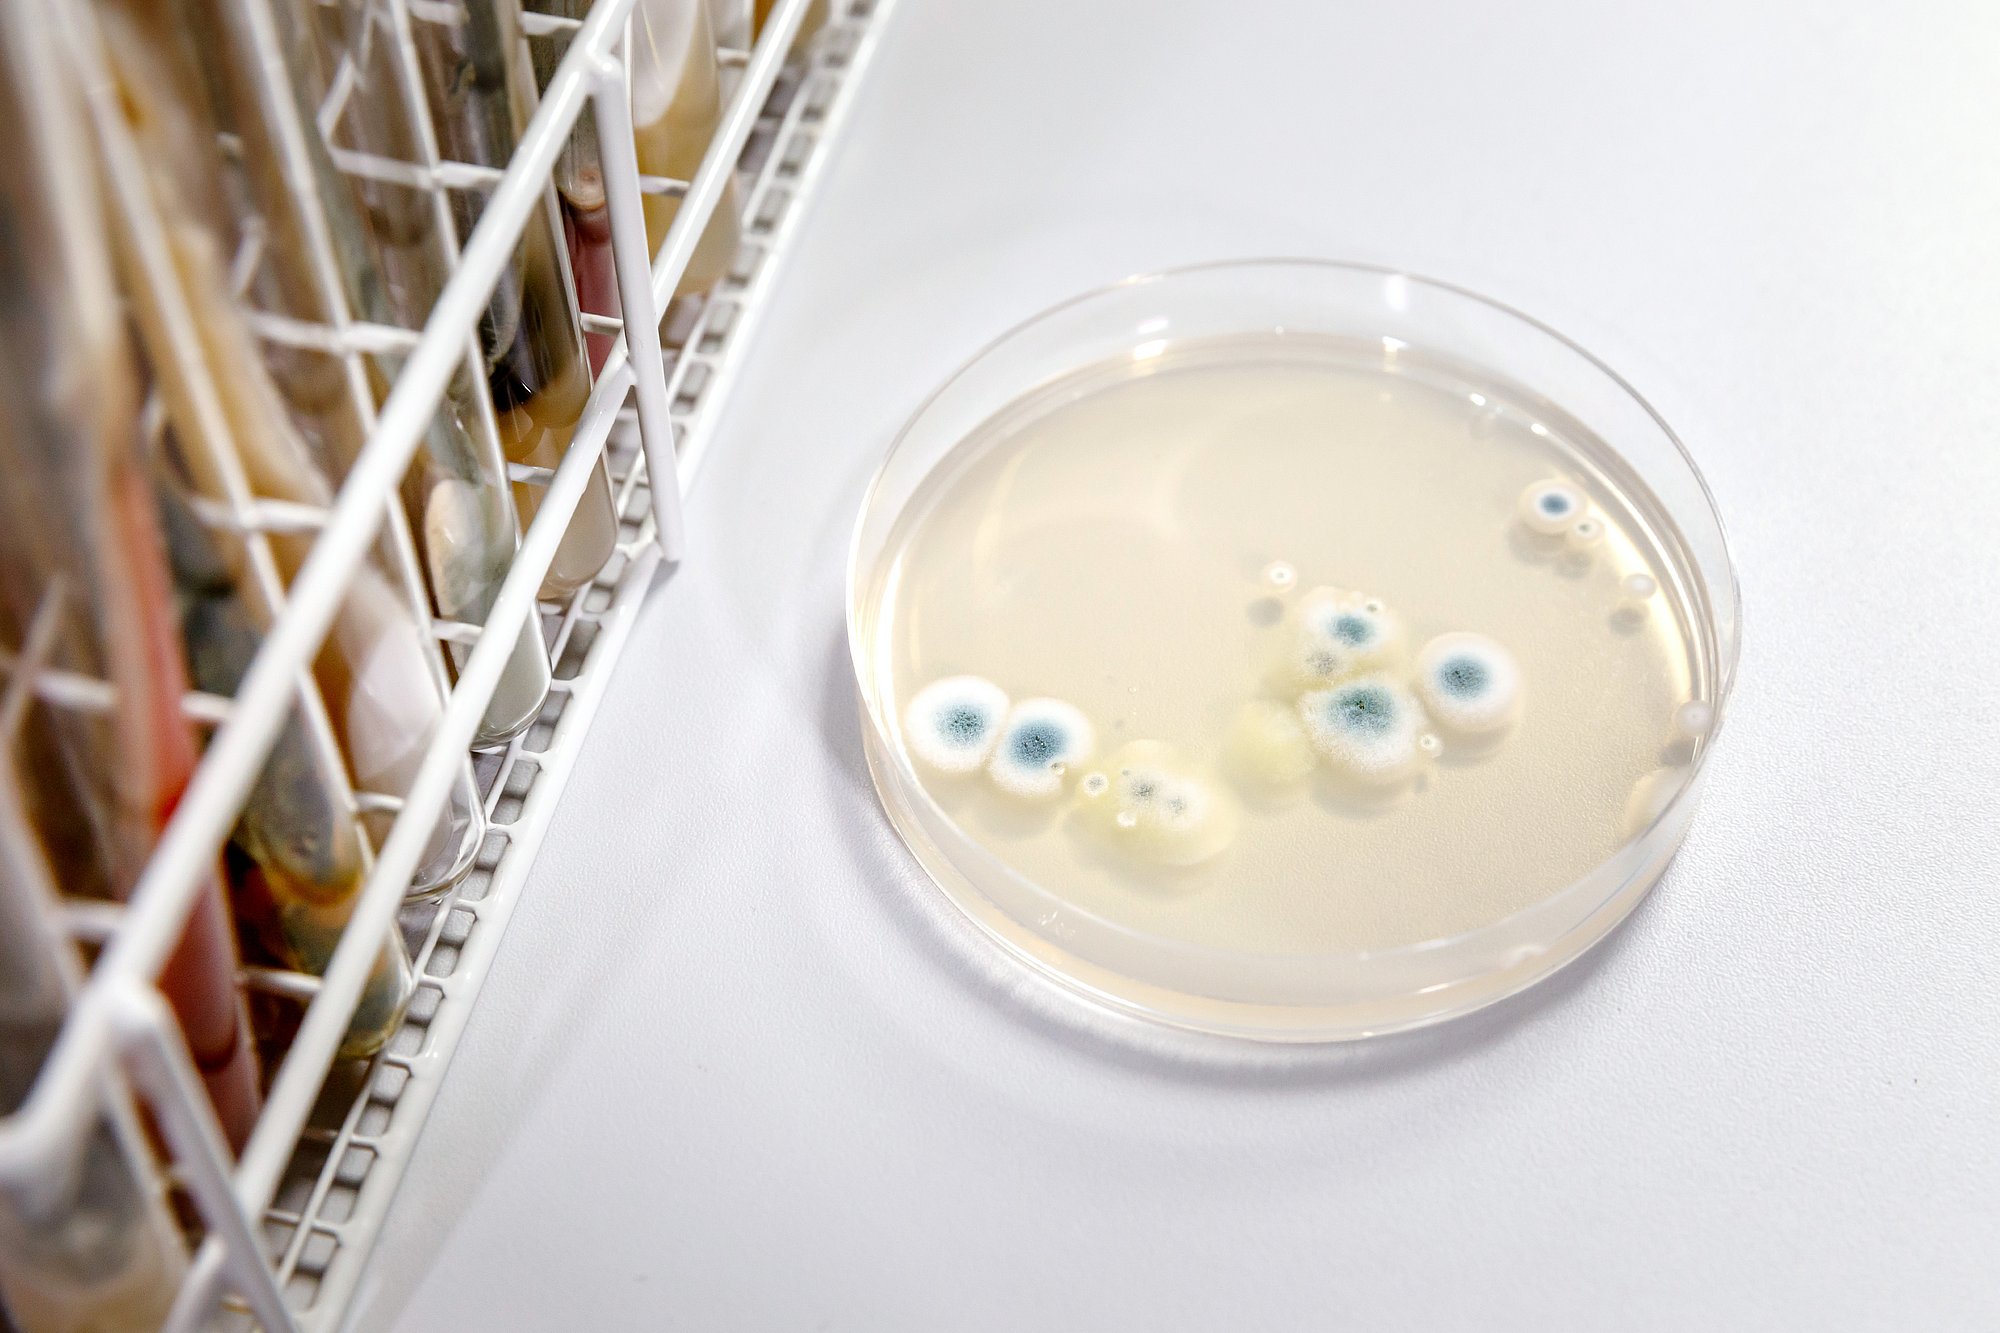

Warum kann Schimmel gefährlich sein?

Ein Befall durch Schimmelpilz ist nicht nur ein unschöner Anblick, sondern kann auch ein Gesundheitsrisiko darstellen. Wenn ein Schimmelbefall in Ihrem Zuhause vorhanden ist, kann dies zu einer Reihe von gesundheitlichen Komplikationen führen. Diese können z.B. Atemwegserkrankungen, Asthma, allergische Reaktionen und andere Krankheiten sein. Daher ist die Entfernung von Schimmel nicht nur aus ästhetischen Gründen notwendig. Die Beseitigung innerhalb der Wohnung sollte also immer priorisiert werden, um Ihre Gesundheit und Sicherheit zu gewährleisten. Durch einen Schimmelbefall können außerdem Einrichtungsgegenstände und Möbel beschädigt werden. Je nach Beschaffenheit bleibt nur noch die Entsorgung der betroffenen Gegenstände.
Wann brauchen Sie einen Schimmel Gutachter in Bülach?

Ein Gutachter für Schimmel ist ein Fachmann, der speziell darauf trainiert ist, den Befall durch Schimmelpilz zu erkennen, zu beurteilen und zu bewerten. Ein Gutachter führt eine gründliche Untersuchung der betroffenen Räume durch. Er nimmt ggf. Proben von den Schimmelpilzkolonien, um festzustellen, welche Arten von Schimmelpilzen vorhanden sind. Ebenso können weitere Analyseverfahren und Messungen (z. B. von der Luft oder Oberflächen etc.) zum Einsatz kommen. Der Gutachter untersucht meist auch die Struktur des Gebäudes, um mögliche Ursachen (wie z.B. ein baulicher Mangel) zu identifizieren. Hier geht es primär um die Identifizierung der Feuchtigkeitsquelle, die für den Schimmelbefall ursächlich ist und eine gutachterliche Stellungnahme hierzu.
In manchen Sachverhalten wird eine Begutachtung und Erstellung eines Gutachtens (beim Thema Schimmel ugs. Schimmel Gutachten bzw. Schimmelgutachten) als schriftlicher Bericht (selten mündliche Stellungnahme) erforderlich. Die Einbeziehung eines Gutachters bzw. Sachverständigen ist dann erforderlich. Dies kann unter anderem z. B. im Falle von Rechtsstreitigkeiten (z. B. bei Mieter - Vermieter Konflikten, Mietminderung etc.), vor Gericht, bei Versicherungsfällen, einem grösseren Wasserschaden oder bei der Abwicklung durch grössere Träger erforderlich sein. Auch die Art und der Umfang des Schadens können über die Notwendigkeit eines Gutachters entscheiden.
Ein Schimmelgutachter kann in vielen Fällen helfen, die Ursache des Schimmelpilzbefalls zu identifizieren und bietet häufig eine Beratung. Wenn Sie den Verdacht haben, dass Schimmel in Ihrem Haus vorhanden ist, kann ein Gutachter helfen, den Umfang des Schimmelbefalls durch eine Untersuchung zu bestimmen und die Ursache zu identifizieren. Ein Gutachter kann auch Empfehlungen zur Sanierung aussprechen, wie Sie die Problematik am besten angehen sollten. Jedoch ist ein Gutachter in der Regel nicht spezialisiert auf die konkrete und tatsächliche Beseitigung von einem Schaden, sondern als Experte auf die gutachterliche Tätigkeit und Beratung ausgerichtet. Das bedeutet, dass Sie zwar ein Gutachten über ggf. die Art des Pilzes, das Ausmass des Befalls und evtl. eine Information zur Ursache und deren Lösung erhalten. Der Schaden und die Ursache (z.B. die feuchte Wand) werden jedoch in der Regel nicht behoben, sondern nachgelagert von einem auf Schimmelentfernung spezialisierten Handwerker, wie ISOTEC.
Wann brauchen Sie stattdessen einen auf Schimmel spezialisierten Handwerker?

Obwohl ein Gutachter / Sachverständiger für Schimmel eine wichtige Rolle bei der Identifizierung und Bewertung des Befalls durch Schimmelpilz spielen kann, ist es wichtig zu beachten, dass in den meisten Fällen dadurch alleine die Feuchte jedoch nicht gestoppt wird und die Beauftragung und Leistung eines Handwerkers erforderlich ist. Meistens liegt die Ursache der Feuchtigkeit für darauf spezialisierte Handwerker in einem sehr gut zu identifizierenden und zu lösenden Bereich. In solchen Fällen benötigen Sie einen darauf spezialisierten Handwerker, der das Problem erkennt und fachgerecht lösen kann, indem er die undichte Stelle oder das Feuchtigkeitsproblem beseitigt. Ein Handwerker kann auch dabei helfen, eine erneute Schimmelbildung zu verhindern, indem er geeignete Massnahmen umsetzt. Tritt ein Schimmelpilzbefall in einem Haus oder Wohnung auf, ist es wichtig schnell zu handeln und den ersten Schritt zu unternehmen, um das Problem so schnell wie möglich zu lösen und weitere Schäden sowie gesundheitliche Risiken zu vermeiden.
Wir von ISOTEC Bülach, ein auf die Entfernung von Feuchtigkeits- und Schimmelschäden spezialisiertes Unternehmen, benötigen aufgrund der eigenen Fachkenntnisse, langjährigen Erfahrung, Sachkunde und Expertise in vielen Fällen keinen zusätzlichen Gutachter, um eine erfolgreiche Sanierung durchzuführen. Nachdem Sie mit uns in Kontakt getreten sind, wird einer unserer Experten aus Bülach durch Messungen und Analyse vor Ort den Schimmelbefall in Augenschein nehmen und die Ursache des Problems identifizieren. Anschliessend wird ein individuelles Lösungskonzept erstellt, das auf die spezifischen Bedürfnisse Ihres Gebäudes und die vorhandene Situation zugeschnitten ist. Zudem wird durch den Einsatz spezieller Abschottungen, Absaugungen und der Einrichtung von Sanierungsbereichen dafür gesorgt, dass Schimmelpilzsporen nicht über die Luft ausserhalb des Sanierungsbereiches verbreitet werden.
Es gibt aber auch einige Sanierungen, bei denen die Zusammenarbeit mit einem Sachverständigen erforderlich ist oder zusätzlich sinnvoll sein kann. Sollte aufgrund der Schadensgrösse, Komplexität oder anderer Notwendigkeiten ein Sachverständiger erforderlich sein, kann die ISOTEC-Gruppe auf ein grosses Netzwerk an Sachverständige zurückgreifen und ggf. unabhängig vermitteln. Wenn eine Versicherung (z.B. häufig bei Wasserschäden etc.) oder anderer Kostenträger involviert ist, könnte die Einbeziehung eines Gutachters oder Sachverständigen von diesen gefordert werden und die Erstellung eines Gutachtens notwendig sein. Stimmen Sie sich hierzu mit dem jeweiligen Träger bzw. den Beteiligten ab. Sind Sie selbst der Auftraggeber, kommen Sie am besten direkt auf uns zu. Das weitere und sinnvolle Vorgehen stimmen wir dann konkret auf Ihren Sachverhalt zugeschnitten ab. Mieter sollten zunächst ihren Vermieter kontaktieren.
Luftkeimmessung als ergänzende Massnahme
Schimmelbefall lässt sich nicht immer mit blossem Auge erkennen, da Schimmelsporen oft unsichtbar in der Raumluft vorhanden sind. Als ergänzende Massnahme kann in manchen Fällen eine Luftkeimmessung mit einem Luftkeimsammler Hinweise auf eine erhöhte Schimmelbelastung liefern. So wird eine objektive Einschätzung der Raumluftqualität möglich, etwa im Rahmen einer Sanierungskontrolle.

Otto Bengtsson
Inhaber / Geschäftsführer